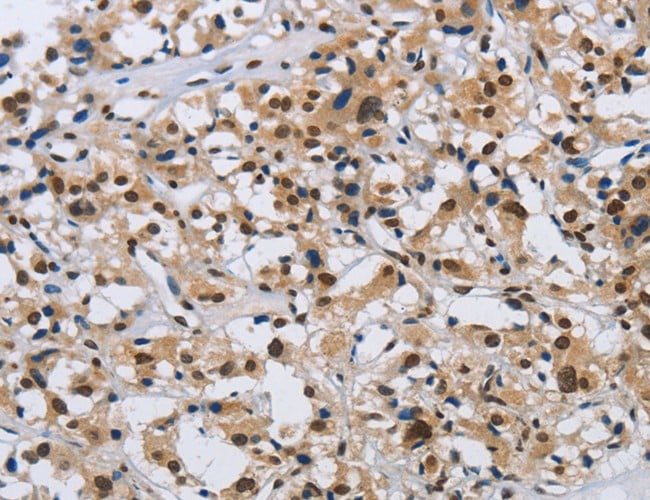
product-image-AAA167159_IHC13.jpg

Importin subunit beta-1 Recombinant Protein | Kpnb1 recombinant protein
Recombinant Mouse Importin subunit beta-1
Gene Names
Kpnb1; IPOB; Impnb; AA409963
Purity
Greater or equal to 85% purity as determined by SDS-PAGE.
Synonyms
Importin subunit beta-1; N/A; Recombinant Mouse Importin subunit beta-1; Karyopherin subunit beta-1; Nuclear factor p97; Pore targeting complex 97 kDa subunit; PTAC97; SCG; Kpnb1 recombinant protein
Host
E Coli or Yeast or Baculovirus or Mammalian Cell
Purity/Purification
Greater or equal to 85% purity as determined by SDS-PAGE.
Form/Format
Lyophilized or liquid (Format to be determined during the manufacturing process)
Sequence Positions
1-876. Full Length
Sequence
MELITILEKTVSPDRLELEAAQKFLERAAVENLPTFLVELSRVLANPGNSQVARVAAGLQIKNSLTSKDPDIKAQYQQRWLAIDANARREVKNYVLQTLGTETYRPSSASQCVAGIACAEIPVSQWPELIPQLVANVTNPNSTEHMKESTLEAIGYICQDIDPEQLQDKSNEILTAIIQGMRKEEPSNNVKLAATNALLNSLEFTKANFDKESERHFIMQVVCEATQCPDTRVRVAALQNLVKIMSLYYQYMETYMGPALFAITIEAMKSDIDEVALQGIEFWSNVCDEEMDLAIEASEAAEQGRPPEHTSKFYAKGALQYLVPILTQTLTKQDENDDDDDWNPCKAAGVCLMLLSTCCEDDIVPHVLPFIKEHIKNPDWRYRDAAVMAFGSILEGPEPNQLKPLVIQAMPTLIELMKDPSVVVRDTTAWTVGRICELLPEAAINDVYLAPLLQCLIEGLSAEPRVASNVCWAFSSLAEAAYEAADVADDQEEPATYCLSSSFELIVQKLLETTDRPDGHQNNLRSSAYESLMEIVKNSAKDCYPAVQKTTLVIMERLQQVLQMESHIQSTSDRIQFNDLQSLLCATLQNVLRKVQHQDALQISDVVMASLLRMFQSTAGSGGVQEDALMAVSTLVEVLGGEFLKYMEAFKPFLGIGLKNYAEYQVCLAAVGLVGDLCRALQSNILPFCDEVMQLLLENLGNENVHRSVKPQILSVFGDIALAIGGEFKKYLEVVLNTLQQASQAQVDKSDFDMVDYLNELRESCLEAYTGIVQGLKGDQENVHPDVMLVQPRVEFILSFIDHIAGDEDHTDGVVACAAGLIGDLCTAFGKDVLKLVEARPMIHELLTEGRRSKTNKAKTLATWATKELRKLKNQA
Preparation and Storage
Store at -20 degree C, for extended storage, conserve at -20 degree C or -80 degree C.
Related Product Information for Kpnb1 recombinant protein
Functions in nuclear protein import, either in association with an adapter protein, like an importin-alpha subunit, which binds to nuclear localization signals (NLS) in cargo substrates, or by acting as autonomous nuclear transport receptor. Acting autonomously, serves itself as NLS receptor. Docking of the importin/substrate complex to the nuclear pore complex (NPC) is mediated by KPNB1 through binding to nucleoporin FxFG repeats and the complex is subsequently translocated through the pore by an energy requiring, Ran-dependent mechanism. At the nucleoplasmic side of the NPC, Ran binds to importin-beta and the three components separate and importin-alpha and -beta are re-exported from the nucleus to the cytoplasm where GTP hydrolysis releases Ran from importin. The directionality of nuclear import is thought to be conferred by an asymmetric distribution of the GTP- and GDP-bound forms of Ran between the cytoplasm and nucleus. Mediates autonomously the nuclear import of ribosomal proteins RPL23A, RPS7 and RPL5. Binds to a beta-like import receptor binding (BIB) domain of RPL23A. In association with IPO7 mediates the nuclear import of H1 histone. In vitro, mediates nuclear import of H2A, H2B, H3 and H4 histones. In case of HIV-1 infection, binds and mediates the nuclear import of HIV-1 Rev. Imports SNAI1 and PRKCI into the nucleus.
References
Localization of the importin-beta gene to mouse chromosome 11D and rat chromosome 10q32.1.Matsuda Y., Hamatani K., Itoh M., Takahashi E., Araki R., Abe M.Genomics 36:213-215(1996) The nuclear pore-targeting complex binds to nuclear pores after association with a karyophile.Imamoto N., Shimamoto T., Kose S., Takao T., Tachibana T., Matsubae M., Sekimoto T., Shimonishi Y., Yoneda Y.FEBS Lett. 368:415-419(1995) Lineage-specific biology revealed by a finished genome assembly of the mouse.Church D.M., Goodstadt L., Hillier L.W., Zody M.C., Goldstein S., She X., Bult C.J., Agarwala R., Cherry J.L., DiCuccio M., Hlavina W., Kapustin Y., Meric P., Maglott D., Birtle Z., Marques A.C., Graves T., Zhou S., Teague B., Potamousis K., Churas C., Place M., Herschleb J., Runnheim R., Forrest D., Amos-Landgraf J., Schwartz D.C., Cheng Z., Lindblad-Toh K., Eichler E.E., Ponting C.P.PLoS Biol. 7:E1000112-E1000112(2009) Mural R.J., Adams M.D., Myers E.W., Smith H.O., Venter J.C. Multiple pathways contribute to nuclear import of core histones.Muehlhaeusser P., Mueller E.-C., Otto A., Kutay U.EMBO Rep. 2:690-696(2001) The C-terminal nuclear localization signal of the sex-determining region Y (SRY) high mobility group domain mediates nuclear import through importin beta 1.Forwood J.K., Harley V., Jans D.A.J. Biol. Chem. 276:46575-46582(2001) Comprehensive identification of phosphorylation sites in postsynaptic density preparations.Trinidad J.C., Specht C.G., Thalhammer A., Schoepfer R., Burlingame A.L.Mol. Cell. Proteomics 5:914-922(2006) Novel importin-alpha family member Kpna7 is required for normal fertility and fecundity in the mouse.Hu J., Wang F., Yuan Y., Zhu X., Wang Y., Zhang Y., Kou Z., Wang S., Gao S.J. Biol. Chem. 285:33113-33122(2010) The adoption of a twisted structure of importin-beta is essential for the protein-protein interaction required for nuclear transport.Lee S.J., Imamoto N., Sakai H., Nakagawa A., Kose S., Koike M., Yamamoto M., Kumasaka T., Yoneda Y., Tsukihara T.J. Mol. Biol. 302:251-264(2000) The structure of importin-beta bound to SREBP-2 nuclear import of a transcription factor.Lee S.J., Sekimoto T., Yamashita E., Nagoshi E., Nakagawa A., Imamoto N., Yoshimura M., Sakai H., Chong K.T., Tsukihara T., Yoneda Y.Science 302:1571-1575(2003)
NCBI and Uniprot Product Information
NCBI GI #
NCBI GeneID
NCBI Accession #
NCBI GenBank Nucleotide #
Molecular Weight
101.2 kDa
NCBI Official Full Name
importin subunit beta-1
NCBI Official Synonym Full Names
karyopherin (importin) beta 1
NCBI Official Symbol
Kpnb1
NCBI Official Synonym Symbols
IPOB; Impnb; AA409963
NCBI Protein Information
importin subunit beta-1
UniProt Protein Name
Importin subunit beta-1
UniProt Gene Name
Kpnb1
UniProt Synonym Gene Names
Impnb; PTAC97
UniProt Entry Name
IMB1_MOUSE
Customer Reviews
Loading reviews...
Share Your Experience
Similar Products
Product Notes
The Kpnb1 kpnb1 (Catalog #AAA113514) is a Recombinant Protein produced from E Coli or Yeast or Baculovirus or Mammalian Cell and is intended for research purposes only. The product is available for immediate purchase. The immunogen sequence is 1-876. Full Length. The amino acid sequence is listed below: MELITILEKT VSPDRLELEA AQKFLERAAV ENLPTFLVEL SRVLANPGNS QVARVAAGLQ IKNSLTSKDP DIKAQYQQRW LAIDANARRE VKNYVLQTLG TETYRPSSAS QCVAGIACAE IPVSQWPELI PQLVANVTNP NSTEHMKEST LEAIGYICQD IDPEQLQDKS NEILTAIIQG MRKEEPSNNV KLAATNALLN SLEFTKANFD KESERHFIMQ VVCEATQCPD TRVRVAALQN LVKIMSLYYQ YMETYMGPAL FAITIEAMKS DIDEVALQGI EFWSNVCDEE MDLAIEASEA AEQGRPPEHT SKFYAKGALQ YLVPILTQTL TKQDENDDDD DWNPCKAAGV CLMLLSTCCE DDIVPHVLPF IKEHIKNPDW RYRDAAVMAF GSILEGPEPN QLKPLVIQAM PTLIELMKDP SVVVRDTTAW TVGRICELLP EAAINDVYLA PLLQCLIEGL SAEPRVASNV CWAFSSLAEA AYEAADVADD QEEPATYCLS SSFELIVQKL LETTDRPDGH QNNLRSSAYE SLMEIVKNSA KDCYPAVQKT TLVIMERLQQ VLQMESHIQS TSDRIQFNDL QSLLCATLQN VLRKVQHQDA LQISDVVMAS LLRMFQSTAG SGGVQEDALM AVSTLVEVLG GEFLKYMEAF KPFLGIGLKN YAEYQVCLAA VGLVGDLCRA LQSNILPFCD EVMQLLLENL GNENVHRSVK PQILSVFGDI ALAIGGEFKK YLEVVLNTLQ QASQAQVDKS DFDMVDYLNE LRESCLEAYT GIVQGLKGDQ ENVHPDVMLV QPRVEFILSF IDHIAGDEDH TDGVVACAAG LIGDLCTAFG KDVLKLVEAR PMIHELLTEG RRSKTNKAKT LATWATKELR KLKNQA. It is sometimes possible for the material contained within the vial of "Importin subunit beta-1, Recombinant Protein" to become dispersed throughout the inside of the vial, particularly around the seal of said vial, during shipment and storage. We always suggest centrifuging these vials to consolidate all of the liquid away from the lid and to the bottom of the vial prior to opening. Please be advised that certain products may require dry ice for shipping and that, if this is the case, an additional dry ice fee may also be required.Precautions
All products in the AAA Biotech catalog are strictly for research-use only, and are absolutely not suitable for use in any sort of medical, therapeutic, prophylactic, in-vivo, or diagnostic capacity. By purchasing a product from AAA Biotech, you are explicitly certifying that said products will be properly tested and used in line with industry standard. AAA Biotech and its authorized distribution partners reserve the right to refuse to fulfill any order if we have any indication that a purchaser may be intending to use a product outside of our accepted criteria.Disclaimer
Though we do strive to guarantee the information represented in this datasheet, AAA Biotech cannot be held responsible for any oversights or imprecisions. AAA Biotech reserves the right to adjust any aspect of this datasheet at any time and without notice. It is the responsibility of the customer to inform AAA Biotech of any product performance issues observed or experienced within 30 days of receipt of said product. To see additional details on this or any of our other policies, please see our Terms & Conditions page.Item has been added to Shopping Cart
If you are ready to order, navigate to Shopping Cart and get ready to checkout.